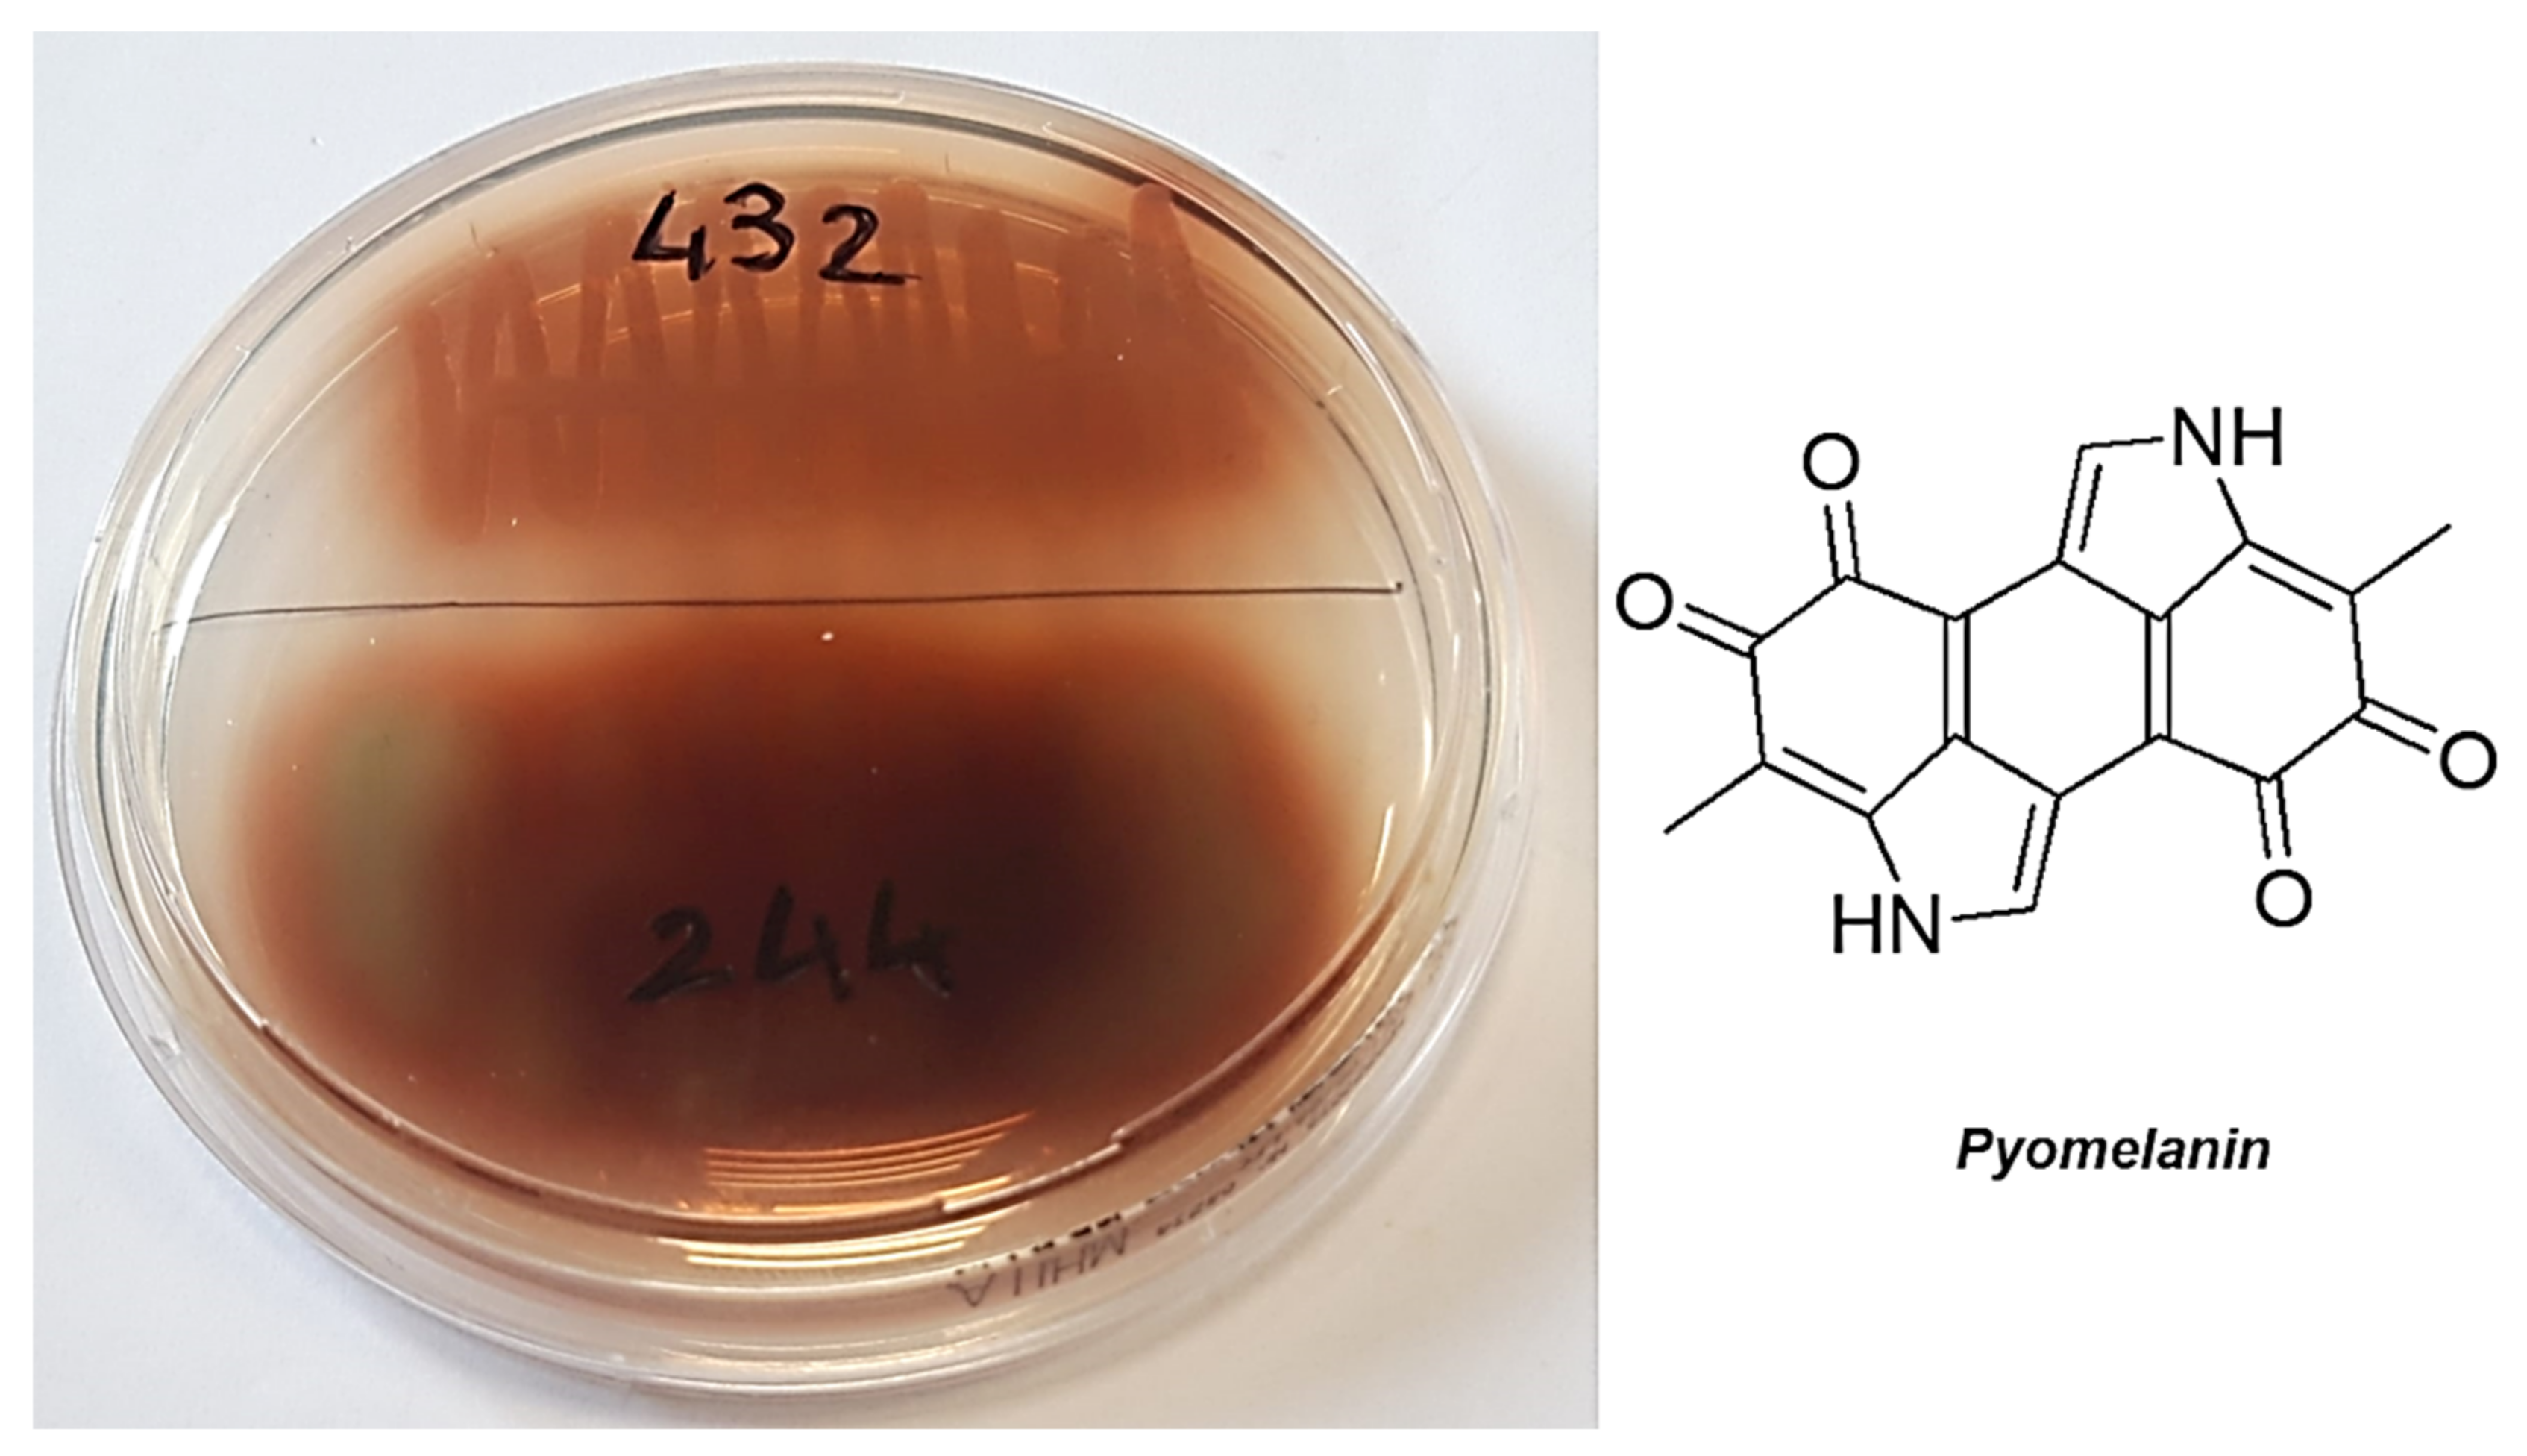
Pharmaceutics 13 01411 g003

Bactericidal Activity of Non-Cytotoxic Cationic Nanoparticles against Clinically and Environmentally Relevant Pseudomonas spp. Isolates
Abstract
:1. Introduction
2. Materials and Methods
2.1. Chemicals and Instruments
2.2. Microbiology
2.2.1. Microorganisms
2.2.2. Determination of the MIC
2.2.3. Killing Curves
2.3. Evaluation of G5-PDK Cytotoxicity
2.3.1. Cell Culture
2.3.2. Viability Assay
2.4. Statistical Analyses
3. Results
3.1. Synthesis and Spectrophotometric Characterization of Lysine-Modified Cationic Dendrimer G5-PDK
3.1.1. Synthesis of the Uncharged Fifth-Generation Polyester-Based Inner Scaffold of G5-PDK (G5-PD-OH)
3.1.2. Synthesis of Lysine-Modified Boc-Protected Dendrimer G5-PD-BK
3.1.3. Acidic Deprotection of G5-PD-BK to Obtain G5-PDK * 128 HCl
3.2. Antibacterial Properties
3.2.1. MICs of G5-PDK
3.2.2. Time-Killing Curves
3.3. Evaluation of Cytotoxicity of G5-PDK on HaCaT Human Keratinocytes Cells
Dose- and Time-Dependent Cytotoxicity Experiments
4. Conclusions
Supplementary Materials
Author Contributions
Funding
Institutional Review Board Statement
Informed Consent Statement
Data Availability Statement
Acknowledgments
Conflicts of Interest
References
- Lipuma, J.J.; Currie, B.J.; Peacock, S.J.; Vandamme, P.A.R. Burkholderia, Stenotrophomonas, Ralstonia, Cupriavidus, Pandoraea, Brevundimonas, Comamonas, Delftia, and Acidovorax. In Manual of Clinical Microbiology; John Wiley & Sons, Ltd.: Hoboken, NJ, USA, 2015; pp. 791–812. ISBN 978-1-68367-280-7. [Google Scholar]
- Vaneechoutte, M.; Nemec, A.; Kämpfer, P.; Cools, P.; Wauters, G. Acinetobacter, Chryseobacterium, Moraxella, and Other Nonfermentative Gram-Negative Rods. In Manual of Clinical Microbiology; John Wiley & Sons, Ltd.: Hoboken, NJ, USA, 2015; pp. 813–837. ISBN 978-1-68367-280-7. [Google Scholar]
- Winn, W.; Allen, S.; Janda, W.; Koneman, E.; Procop, G.; Schreckenberger, P.; Woods, G. Color Atlas and Textbook of Diagnostic Microbiology, 6th ed.; Lippincott Williams & Wilkins: Philadelphia, PA, USA, 2006. [Google Scholar]
- Arnold, D.L.; Preston, G.M. Pseudomonas Syringae: Enterprising Epiphyte and Stealthy Parasite. Microbiology 2019, 165, 251–253. [Google Scholar] [CrossRef] [PubMed]
- Brady, M.T.; Leber, A. Less Commonly Encountered Nonenteric Gram-Negative Bacilli. In Principles and Practice of Pediatric Infectious Diseases, 5th ed.; Long, S.S., Prober, C.G., Fischer, M., Eds.; Elsevier: Amsterdam, The Netherlands; Oland, Sweden, 2018; pp. 855–859.e3. [Google Scholar] [CrossRef]
- Vanneste, J.L. Plant & Food Research, Private Bag 92169, Auckland 1142, New Zealand (Revised October 2011). Available online: https://resistance.nzpps.org/index.php?p=fungicides/streptomycin (accessed on 26 July 2021).
- Marqués, S.; Ramos, J.L. Transcriptional Control of the Pseudomonas Putida TOL Plasmid Catabolic Pathways. Mol. Microbiol. 1993, 9, 923–929. [Google Scholar] [CrossRef]
- Verbist, L. Epidemiology and sensitivity of 8625 ICU and hematology/oncology bacterial isolates in Europe. International Study Group. Scand. J. Infect. Diseases. Suppl. 1993, 91, 14–24. [Google Scholar]
- Pier, G.B.; Ramphal, R. Pseudomonas aeruginosa. In Mandell, Douglas, and Bennett’s Principles and Practice of Infectious Diseases, 6th ed.; Mandell, G.L., Bennett, J.E., Dolin, R., Eds.; Elsevier: Amsterdam, The Netherlands; Churchill Livingstone: New York, NY, USA, 2004; pp. 2587–2615. [Google Scholar]
- Bodey, G.P.; Bolivar, R.; Fainstein, V.; Jadeja, L. Infections Caused by Pseudomonas Aeruginosa. Rev. Infect. Dis. 1983, 5, 279–313. [Google Scholar] [CrossRef]
- Hsueh, P.-R.; Teng, L.-J.; Pan, H.-J.; Chen, Y.-C.; Sun, C.-C.; Ho, S.-W.; Luh, K.-T. Outbreak of Pseudomonas Fluorescens Bacteremia among Oncology Patients. J. Clin. Microbiol. 1998, 36, 2914–2917. [Google Scholar] [CrossRef] [Green Version]
- Sutter, V.L.; Hurst, V.; Landucci, A.O.J. Pseudomonads in Human Saliva. J. Dent. Res. 1966, 45, 1800–1803. [Google Scholar] [CrossRef]
- Von Graevenitz, A. Clinical microbiology of unusual Pseudomonas species. Prog. Clin. Pathol. 1973, 5, 185–218. [Google Scholar] [PubMed]
- Stenhouse, M.A.E.; Milner, L.V. A Survey of Cold-Growing Gram-Negative Organisms Isolated from the Skin of Prospective Blood Donors. Transfus. Med. 1992, 2, 235–237. [Google Scholar] [CrossRef]
- Sarubbi, J.; Felix, A.; Wilson, M.B.; Lee, M.; Brokopp, C. Nosocomial Meningitis and Bacteremia Due to Contaminated Amphotericin B. JAMA 1978, 239, 416–418. [Google Scholar] [CrossRef]
- Murray, A.E.; Bartzokas, C.A.; Shepherd, A.J.N.; Roberts, F.M. Blood Transfusion-Associated Pseudomonas fluorescens Septicaemia: Is This an Increasing Problem? J. Hosp. Infect. 1987, 9, 243–248. [Google Scholar] [CrossRef]
- Gibb, A.P.; Martin, K.; Davidson, G.; Walker, B.; Murphy, W. Bacterial Growth in Blood for Transfusion. Lancet 1992, 340, 1222–1223. [Google Scholar] [CrossRef]
- Gottlieb, T. Hazards of Bacterial Contamination of Blood Products. Anaesth. Intensive Care 1993, 21, 20–23. [Google Scholar] [CrossRef] [PubMed] [Green Version]
- Oie, S.; Kamiya, A. Microbial contamination of antiseptics and disinfectants. Am. J. Infect. Control 1996, 24, 389–395. [Google Scholar] [CrossRef]
- Whyte, A.; Lafong, C.; Malone, J.; Golda, B.P. Letters to the Editor. J. Hosp. Infect. 1999, 42, 342–343. [Google Scholar] [CrossRef]
- Smith, J.; Ashhurst-Smith, C.; Norton, R. Pseudomonas fluorescens Pseudobacteraemia: A Cautionary Lesson. J. Paediatr. Child Health 2002, 38, 63–65. [Google Scholar] [CrossRef] [PubMed]
- Hakuno, H.; Yamamoto, M.; Oie, S.; Kamiya, A. Microbial contamination of disinfectants used for intermittent self-catheterization. Jpn. J. Infect. Dis. 2010, 63, 277–279. [Google Scholar]
- Scales, B.S.; Dickson, R.P.; LiPuma, J.J.; Huffnagle, G.B. Microbiology, genomics, and clinical significance of the Pseudomonas fluorescens species complex, an unappreciated colonizer of humans. Clin. Microbiol. Rev. 2014, 27, 927–948. [Google Scholar] [CrossRef] [PubMed] [Green Version]
- Yamamoto, M.; Ina, Y.; Takada, K.; Noda, M.; Morishita, M.; Senda, Y.; Torii, Y.; Kakihara, H.; Yoshikawa, K.; Sugiura, T. Therapeutic efficacy of imipenem/cilastatin sodium on respiratory tract infections in lung cancer patients. Jpn. J. Antibiot. 1991, 44, 388–397. [Google Scholar]
- Osawa, K.; Nakajima, M.; Kataoka, N.; Arakawa, S.; Kamidono, S. Evaluation of Antibacterial Efficacy of Drugs for Urinary Tract Infections by Genotyping Based on Pulsed-Field Gel Electrophoresis (PFGE). J. Infect. Chemother. 2002, 8, 353–357. [Google Scholar] [CrossRef]
- Khabbaz, R.F.; Arnow, P.M.; Highsmith, A.K.; Herwaldt, L.A.; Chou, T.; Jarvis, W.R.; Lerche, N.W.; Allen, J.R. Pseudomonas fluorescens Bacteremia from Blood Transfusion. Am. J. Med. 1984, 76, 62–68. [Google Scholar] [CrossRef]
- Scott, J.; Boulton, F.; Govan, J.; Miles, R.; McClelland, D.; Prowse, C. A Fatal Transfusion Reaction Associated with Blood Contaminated with Pseudomonas fluorescens. Vox Sang. 1988, 54, 201–204. [Google Scholar] [CrossRef]
- Gershman, M.D.; Kennedy, D.J.; Noble-Wang, J.; Kim, C.; Gullion, J.; Kacica, M.; Jensen, B.; Pascoe, N.; Saiman, L.; McHale, J.; et al. Multistate Outbreak of Pseudomonas fluorescens Bloodstream Infection after Exposure to Contaminated Heparinized Saline Flush Prepared by a Compounding Pharmacy. Clin. Infect. Dis. 2008, 47, 1372–1379. [Google Scholar] [CrossRef] [Green Version]
- Siebor, E.; Llanes, C.; Lafon, I.; Ogier-Desserrey, A.; Duez, J.M.; Pechinot, A.; Caillot, D.; Grandjean, M.; Sixt, N.; Neuwirth, C. Presumed Pseudobacteremia Outbreak Resulting from Contamination of Proportional Disinfectant Dispenser. Eur. J. Clin. Microbiol. Infect. Dis. 2007, 26, 195–198. [Google Scholar] [CrossRef]
- Namnyak, S.; Hussain, S.; Davalle, J.; Roker, K.; Strickland, M. Contaminated lithium heparin bottles as a source of pseudobacteraemia due to Pseudomonas fluorescens. J. Hosp. Infect. 1999, 41, 23–28. [Google Scholar] [CrossRef]
- Taber, T.E.; Hegeman, T.F.; York, S.M.; Kinney, R.A.; Webb, D.H. Treatment of Pseudomonas Infections in Peritoneal Dialysis Patients. Perit. Dial. Int. 1991, 11, 213–216. [Google Scholar] [CrossRef]
- Ramirez, R.J.; Quintana, P.P.; Galvan, J.J.C.; Diaz, J.G. Colestasis intra hepatica severa en el curso de sepsis por Pseudomonas fluorescens. Rev. Clin. Esp. 1989, 185, 106–107. [Google Scholar]
- Jackson, M.K.; Phillips, S.N. Necrotizing Hepatitis in Pet Birds Associated with Pseudomonas fluorescens. Avian Dis. 1996, 40, 473–476. [Google Scholar] [CrossRef]
- Centers for Disease Control and Prevention. Pseudomonas bloodstream infections associated with a heparin/saline flush—Missouri, New York, Texas, and Michigan, 2004–2005. MMWR Morb. Mortal Wkly. Rep. 2005, 54, 269–272. Available online: http://www.cdc.gov/MMWR/preview/mmwrhtml/mm5411a1.htm (accessed on 6 September 2021).
- Centers for Disease Control and Prevention. Update: Delayed onset Pseudomonas fluorescens bloodstream infections alter exposure to contaminated heparin flush—Michigan and South Dakota, 2005–2006. MMWR Morb. Mortal Wkly. Rep. 2006, 55, 961–963. Available online: http://www.cdc.gov/MMWR/preview/mmwrhtml/mm5535a2.htm (accessed on 6 September 2021).
- Anaissie, E.J.; Penzak, S.R.; Dignani, M.C. The Hospital Water Supply as a Source of Nosocomial Infections: A Plea for Action. Arch. Intern. Med. 2002, 162, 1483–1492. [Google Scholar] [CrossRef] [Green Version]
- Wong, V.; Levi, K.; Baddal, B.t; Turton, J.; Boswell, T.C. Spread of Pseudomonas fluorescens Due to Contaminated Drinking Water in a Bone Marrow Transplant Unit. J. Clin. Microbiol. 2011, 49, 2093–2096. [Google Scholar] [CrossRef] [Green Version]
- Anzai, Y.; Kim, H.; Park, J.Y.; Wakabayashi, H.; Oyaizu, H. Phylogenetic Affiliation of the Pseudomonads Based on 16S RRNA Sequence. Int. J. Syst. Evol. Microbiol. 2000, 50, 1563–1589. [Google Scholar] [CrossRef] [Green Version]
- Nikolaidis, M.; Mossialos, D.; Oliver, S.G.; Amoutzias, G.D. Comparative Analysis of the Core Proteomes among the Pseudomonas Major Evolutionary Groups Reveals Species-Specific Adaptations for Pseudomonas Aeruginosa and Pseudomonas Chlororaphis. Diversity 2020, 12, 289. [Google Scholar] [CrossRef]
- Gomes, N.C.; Kosheleva, I.A.; Abraham, W.R.; Smalla, K. Effects of the inoculant strain Pseudomonas putida KT2442 (pNF142) and of naphthalene contamination on the soil bacterial community. FEMS Microbiol. Ecol. 2005, 54, 21–33. [Google Scholar] [CrossRef] [PubMed]
- Britt, R.R. Immortal Polystyrene Foam Meets its Enemy. LiveScience 2006. Available online: https://www.livescience.com/605-immortal-polystyrene-foam-meets-enemy.html (accessed on 8 July 2021).
- Ward, P.G.; Goff, M.; Donner, M.; Kaminsky, W.; O’Connor, K.E. A Two Step Chemo-Biotechnological Conversion of Polystyrene to a Biodegradable Thermoplastic. Environ. Sci. Technol. 2006, 40, 2433–2437. [Google Scholar] [CrossRef]
- Amer, G.; Utkhede, R. Development of Formulations of Biological Agents for Management of Root Rot of Lettuce and Cucumber. Can. J. Microbiol. 2000, 46, 809–816. [Google Scholar] [CrossRef]
- Validov, S.; Kamilova, F.; Qi, S.; Stephan, D.; Wang, J.J.; Makarova, N.; Lugtenberg, B. Selection of Bacteria Able to Control Fusarium oxysporum f. Sp. Radicis-lycopersici in Stonewool Substrate. J. Appl. Microbiol. 2007, 102, 461–471. [Google Scholar] [CrossRef]
- Harmon, K. Newly Discovered Bacteria Lives on Caffeine 2011. Available online: http://blogs.scientificamerican.com/observations/2011/05/24/newly-discovered-bacteria-lives-on-caffeine (accessed on 8 July 2021).
- Summers, R.M.; Louie, T.M.; Yu, C.L.; Subramanian, M. Characterization of a Broad-Specificity Non-Haem Iron N-Demethylase from Pseudomonas Putida CBB5 Capable of Utilizing Several Purine Alkaloids as Sole Carbon and Nitrogen Source. Microbiology 2011, 157, 583–592. [Google Scholar] [CrossRef] [Green Version]
- Poblete-Castro, I.; Becker, J.; Dohnt, K.; dos Santos, V.M.; Wittmann, C. Industrial Biotechnology of Pseudomonas Putida and Related Species. Appl. Microbiol. Biotechnol. 2012, 93, 2279–2290. [Google Scholar] [CrossRef]
- Thomas, B.S.; Okamoto, K.; Bankowski, M.J.; Seto, T.B. A Lethal Case of Pseudomonas Putida Bacteremia Due to Soft Tissue Infection. Infect. Dis. Clin. Pract. 2013, 21, 147–213. [Google Scholar] [CrossRef] [Green Version]
- Tan, G.; Xi, Y.; Yuan, P.; Sun, Z.; Yang, D. Risk Factors and Antimicrobial Resistance Profiles of Pseudomonas Putida Infection in Central China, 2010–2017. Medicine 2019, 98, e17812. [Google Scholar] [CrossRef]
- Romney, M.; Sherlock, C.; Stephens, G.; Clarke, A. Pseudo-outbreak of Pseudomonas putida in a hospital outpatient clinic originating from a contaminated commercial anti-fog solution. Can. Commun. Dis. Rep. 2000, 26, 183–184. [Google Scholar]
- Perz Joseph, F.; Craig Allen, S.; Stratton Charles, W.; Bodner Stanley, J.; Phillips Walter, E. Schaffner William Pseudomonas Putida Septicemia in a Special Care Nursery Due to Contaminated Flush Solutions Prepared in a Hospital Pharmacy. J. Clin. Microbiol. 2005, 43, 5316–5318. [Google Scholar] [CrossRef] [Green Version]
- Lee, S.M.; Kim, M.K.; Lee, J.L.; Wee, W.R.; Lee, J.H. Experience of Comamonas Acidovorans Keratitis with Delayed Onset and Treatment Response in Immunocompromised Cornea. Korean J. Ophthalmol. 2008, 22, 49–52. [Google Scholar] [CrossRef] [Green Version]
- Stampi, S.; Zanetti, F.; Bergamaschi, A.; De Luca, G. Comamonas Acidovorans Contamination of Dental Unit Waters. Lett. Appl. Microbiol. 1999, 29, 52–55. [Google Scholar] [CrossRef] [Green Version]
- Ryan, M.P.; Pembroke, J.T.; Adley, C.C. Ralstonia Pickettii: A Persistent Gram-Negative Nosocomial Infectious Organism. J. Hosp. Infect. 2006, 62, 278–284. [Google Scholar] [CrossRef]
- Schito, A.M.; Alfei, S. Antibacterial Activity of Non-Cytotoxic, Amino Acid-Modified Polycationic Dendrimers against Pseudomonas aeruginosa and Other Non-Fermenting Gram-Negative Bacteria. Polymers 2020, 12, 1818. [Google Scholar] [CrossRef]
- Zagorec, M.; Champomier-Vergès, M.-C. Chapter 6-Meat Microbiology and Spoilage. In Lawrie’s Meat Science, 8th ed.; Toldra’, F., Ed.; Woodhead Publishing: Sawston, UK, 2017; pp. 187–203. ISBN 978-0-08-100694-8. [Google Scholar]
- Dudhani, R.V.; Turnidge, J.D.; Coulthard, K.; Milne, R.W.; Rayner, C.R.; Li, J.; Nation, R.L. Elucidation of the pharmacokinetic/pharmacodynamic determinant of colistin activity against Pseudomonas aeruginosa in murine thigh and lung infection models. Antimicrob. Agents Chemother. 2010, 54, 1117–1124. [Google Scholar] [CrossRef] [Green Version]
- Yayan, J.; Ghebremedhin, B.; Rasche, K. Antibiotic Resistance of Pseudomonas aeruginosa in Pneumonia at a Single University Hospital Center in Germany over a 10-Year Period. PLoS ONE 2015, 10, e0139836. [Google Scholar] [CrossRef] [Green Version]
- Chung, E.S.; Lee, J.Y.; Rhee, J.Y.; Ko, K.S. Colistin resistance in Pseudomonas aeruginosa that is not linked to arnB. J. Med Microbiol. 2017, 66, 833–841. [Google Scholar] [CrossRef] [PubMed]
- Alfei, S.; Caviglia, D.; Piatti, G.; Zuccari, G.; Schito, A.M. Bactericidal Activity of a Self-Biodegradable Lysine-Containing Dendrimer against Clinical Isolates of Acinetobacter Genus. Int. J. Mol. Sci. 2021, 22, 7274. [Google Scholar] [CrossRef]
- EUCAST. European Committee on Antimicrobial Susceptibility Testing. Available online: https://www.eucast.org/ast_of_bacteria/ (accessed on 8 July 2020).
- Schito, A.M.; Piatti, G.; Stauder, M.; Bisio, A.; Giacomelli, E.; Romussi, G.; Pruzzo, C. Effects of demethylfruticuline A and fruticuline A from Salvia corrugata Vahl. on biofilm production in vitro by multiresistant strains of Staphylococcus aureus, Staphylococcus epidermidis and Enterococcus faecalis. Int. J. Antimicrob. Agents 2011, 37, 129–134. [Google Scholar] [CrossRef] [Green Version]
- Di Paolo, D.; Pastorino, F.; Zuccari, G.; Caffa, I.; Loi, M.; Marimpietri, D.; Brignole, C.; Perri, P.; Cilli, M.; Nico, B.; et al. Enhanced Anti-Tumor and Anti-Angiogenic Efficacy of a Novel Liposomal Fenretinide on Human Neuroblastoma. J. Control. Release 2013, 170, 445–451. [Google Scholar] [CrossRef]
- Ihre, H.; Hult, A.; Fréchet, J.M.J.; Gitsov, I. Double-stage convergent approach for the synthesis of functionalized dendritic aliphatic polyesters based on 2,2-bis(hydroxymethyl)propionic acid. Macromolecules 1998, 31, 4061–4068. [Google Scholar] [CrossRef]
- Alfei, S.; Castellaro, S.; Taptue, G.B. Synthesis and NMR characterization of dendrimers based on 2,2-bis-(hydroxymethyl)-propanoic acid (bis-HMPA) containing peripheral amino acid residues for gene transfection. Org. Commun. 2017, 10, 144–177. [Google Scholar] [CrossRef]
- Alfei, S.; Castellaro, S. Synthesis and characterization of polyesterbased dendrimers containing peripheral arginine or mixed amino acids as potential vectors for gene and drug delivery. Macromol. Res. 2017, 25, 1172–1186. [Google Scholar] [CrossRef]
- Alfei, S.; Catena, S.; Turrini, F. Biodegradable and biocompatible spherical dendrimer nanoparticles with a gallic acid shell and a double-acting strong antioxidant activity as potential device to fight diseases from “oxidative stress”. Drug Deliv. Transl. Res. 2019, 10, 259–270. [Google Scholar] [CrossRef]
- Alfei, S.; Oliveri, P.; Malegori, C. Assessment of the Efficiency of a Nanospherical Gallic Acid Dendrimer for Long-Term Preservation of Essential Oils: An Integrated Chemometric-Assisted FTIR Study. ChemistrySelect 2019, 4, 8891–8901. [Google Scholar] [CrossRef]
- Alfei, S.; Signorello, M.G.; Schito, A.M.; Catena, S.; Turrini, F. Reshaped as polyester-based nanoparticles, gallic acid inhibits platelet aggregation, reactive oxygen species production and multi-resistant Gram-positive bacteria with an efficiency never obtained. Nanoscale Adv. 2019, 1, 4148–4157. [Google Scholar] [CrossRef] [Green Version]
- Abu, E.A.; Su, S.; Sallans, L.; Boissy, R.E.; Greatens, A.; Heineman, W.R.; Hassett, D.J. Cyclic Voltammetric, Fluorescence and Biological Analysis of Purified Aeruginosin A, a Secreted Red Pigment of Pseudomonas Aeruginosa PAO1. Microbiology 2013, 159, 1736–1747. [Google Scholar] [CrossRef]
- Ogunnariwo, J.; Hamilton-Miller, J.M.T. Brown- and Red-Pigmented Pseudomonas Aeruginosa: Differentiation Between Melanin and Pyorubrin. J. Med. Microbiol. 1975, 8, 199–203. [Google Scholar] [CrossRef] [Green Version]
- Schalk, I.J.; Guillon, L. Pyoverdine Biosynthesis and Secretion in Pseudomonas Aeruginosa: Implications for Metal Homeostasis. Environ. Microbiol. 2013, 15, 1661–1673. [Google Scholar] [CrossRef]
- Visca, P.; Imperi, F.; Lamont, I.L. Pyoverdine Siderophores: From Biogenesis to Biosignificance. Trends Microbiol. 2007, 15, 22–30. [Google Scholar] [CrossRef] [PubMed]
- Dertz, E.A.; Raymond, K.N. Siderophores and Transferrins. In Comprehensive Coordination Chemistry II; McCleverty, J.A., Meyer, T.J., Eds.; Pergamon: Oxford, UK, 2003; pp. 141–168. ISBN 978-0-08-043748-4. [Google Scholar]
- Meyer, J.M. Pyoverdines: Pigments, siderophores and potential taxonomic markers of fluorescent Pseudomonas species. Arch. Microbiol. 2000, 174, 135–142. [Google Scholar] [CrossRef] [PubMed]
- Mavrodi, D.V.; Bonsall, R.F.; Delaney, S.M.; Soule, M.J.; Phillips, G.; Thomashow, L.S. Functional Analysis of Genes for Biosynthesis of Pyocyanin and Phenazine-1-Carboxamide from Pseudomonas Aeruginosa PAO1. J. Bacteriol. 2001, 183, 6454–6465. [Google Scholar] [CrossRef] [Green Version]
- Jayaseelan, S.; Ramaswamy, D.; Dharmaraj, S. Pyocyanin: Production, Applications, Challenges and New Insights. World J. Microbiol. Biotechnol. 2014, 30, 1159–1168. [Google Scholar] [CrossRef] [PubMed]
- Meirelles, L.A.; Perry, E.K.; Bergkessel, M.; Newman, D.K. Bacterial Defenses against a Natural Antibiotic Promote Collateral Resilience to Clinical Antibiotics. PLoS Biol. 2021, 19, e3001093. [Google Scholar] [CrossRef]
- Yabuuchi, E.; Ohyama, A. Characterization of “Pyomelanin”-Producing Strains of Pseudomonas aeruginosa. Int. J. Syst. Bacteriol. 1972, 22, 53–64. [Google Scholar] [CrossRef] [Green Version]
- Hyldgaard, M.; Meyer, R.L.; Peng, M.; Hibberd, A.A.; Fischer, J.; Sigmundsson, A.; Mygind, T. Binary combination of epsilon-poly-l-lysine and isoeugenol affect progression of spoilage microbiota in fresh turkey meat, and delay onset of spoilage in Pseudomonas putida challenged meat. Int. J. Food Microbiol. 2015, 215, 131–142. [Google Scholar] [CrossRef]
- Weiyang, L.; Shrinivas, V.; Guansheng, Z.; Bisha, D.; Tan, P.K.J.; Xu, L.; Weimin, F.; Yi, Y.Y. Antimicrobial polymers as therapeutics for treatment of multidrug-resistant Klebsiella pneumoniae lung infection. Acta Biomater. 2018, 78, 78–88. [Google Scholar]
- Grace, J.L.; Huang, J.X.; Cheah, S.-E.; Truong, N.P.; Cooper, M.A.; Li, J.; Davis, T.P.; Quinn, J.F.; Velkov, T.; Whittaker, M.R. Antibacterial Low Molecular Weight Cationic Polymers: Dissecting the Contribution of Hydrophobicity, Chain Length and Charge to Activity. RSC Adv. 2016, 6, 15469–15477. [Google Scholar] [CrossRef]
- Menkissoglu-Spiroudi, U.; Karamanoli, K.; Spyroudis, S.; Constantinidou, H.-I.A. Hypervalent Iodine Compounds as Potent Antibacterial Agents against Ice Nucleation Active (INA) Pseudomonas Syringae. J. Agric. Food Chem. 2001, 49, 3746–3752. [Google Scholar] [CrossRef] [PubMed]
- Edwards-Gayle, C.J.C.; Barrett, G.; Roy, S.; Castelletto, V.; Seitsonen, J.; Ruokolainen, J.; Hamley, I.W. Selective Antibacterial Activity and Lipid Membrane Interactions of Arginine-Rich Amphiphilic Peptides. ACS Appl. Bio Mater. 2020, 3, 1165–1175. [Google Scholar] [CrossRef] [PubMed]
- Sohn, H.-R.; Bae, J.-H.; Hou, C.T.; Kim, H.-R. Antibacterial Activity of a 7,10-Dihydroxy-8(E)-Octadecenoic Acid against Plant Pathogenic Bacteria. Enzym. Microb. Technol. 2013, 53, 152–153. [Google Scholar] [CrossRef]
- Cameron, A.; Zoysa, G.H.D.; Sarojini, V. Antimicrobial Peptides against Pseudomonas Syringae Pv. Actinidiae and Erwinia Amylovora: Chemical Synthesis, Secondary Structure, Efficacy, and Mechanistic Investigations. Pept. Sci. 2014, 102, 88–96. [Google Scholar] [CrossRef] [PubMed]
- Landman, D.; Georgescu, C.; Martin, D.A.; Quale, J. Polymyxins revisited. Clin. Microbiol. Rev. 2008, 21, 449–465. [Google Scholar] [CrossRef] [PubMed] [Green Version]
- Keepers, T.R.; Gomez, M.; Celeri, C.; Nichols, W.W.; Krause, K.M. Bactericidal Activity, Absence of Serum Effect, and Time-Kill Kinetics of Ceftazidime-Avibactam against β-Lactamase-Producing Enterobacteriaceae and Pseudomonas Aeruginosa. Antimicrob. Agents Chemother. 2014, 58, 5297–5305. [Google Scholar] [CrossRef] [PubMed] [Green Version]
- Wu, D.C.; Chan, W.W.; Metelitsa, A.I.; Fiorillo, L.; Lin, A.N. Pseudomonas Skin Infection. Am. J. Clin. Dermatol. 2011, 12, 157–169. [Google Scholar] [CrossRef]
- Peña-Morán, O.A.; Villarreal, M.L.; Álvarez-Berber, L.; Meneses-Acosta, A.; Rodríguez-López, V. Cytotoxicity, Post-Treatment Recovery, and Selectivity Analysis of Naturally Occurring Podophyllotoxins from Bursera Fagaroides Var. Fagaroides on Breast Cancer Cell Lines. Molecules 2016, 21, 1013. [Google Scholar] [CrossRef]
- Awouafack, M.D.; McGaw, L.J.; Gottfried, S.; Mbouangouere, R.; Tane, P.; Spiteller, M.; Eloff, J.N. Antimicrobial Activity and Cytotoxicity of the Ethanol Extract, Fractions and Eight Compounds Isolated from Eriosema Robustum (Fabaceae). BMC Complementary Altern. Med. 2013, 13, 289. [Google Scholar] [CrossRef] [Green Version]
- Weerapreeyakul, N.; Nonpunya, A.; Barusrux, S.; Thitimetharoch, T.; Sripanidkulchai, B. Evaluation of the Anticancer Potential of Six Herbs against a Hepatoma Cell Line. Chin. Med. 2012, 7, 15. [Google Scholar] [CrossRef] [PubMed] [Green Version]
- Adamu, M.; Naidoo, V.; Eloff, J.N. The Antibacterial Activity, Antioxidant Activity and Selectivity Index of Leaf Extracts of Thirteen South African Tree Species Used in Ethnoveterinary Medicine to Treat Helminth Infections. BMC Vet. Res. 2014, 10, 52. [Google Scholar] [CrossRef] [Green Version]
- Adamu, M.; Naidoo, V.; Eloff, J.N. Efficacy and Toxicity of Thirteen Plant Leaf Acetone Extracts Used in Ethnoveterinary Medicine in South Africa on Egg Hatching and Larval Development of Haemonchus Contortus. BMC Vet. Res. 2013, 9, 38. [Google Scholar] [CrossRef] [PubMed] [Green Version]
- Famuyide, I.M.; Aro, A.O.; Fasina, F.O.; Eloff, J.N.; McGaw, L.J. Antibacterial and Antibiofilm Activity of Acetone Leaf Extracts of Nine Under-Investigated South African Eugenia and Syzygium (Myrtaceae) Species and Their Selectivity Indices. BMC Complementary Altern. Med. 2019, 19, 141. [Google Scholar] [CrossRef] [Green Version]
- Nogueira, F.; do Rosario, V.E. Methods for assessment of antimalarial activity in the different phases of the Plasmodiumlife cycle. Rev. Pan-Amaz. Saúde 2010, 1, 109–124. [Google Scholar] [CrossRef]

| Analysis | G5-PD-OH | G5-PD-BK | ||
|---|---|---|---|---|
| FTIR (cm−1) | OH C-H alkyl C=O esters | 3436 2936 1737 | NH C-H alkyl C=ONH urethane -C=O esters NH banding | 3380 2870, 2932, 2979 1710 1747 1727 |
| 1H NMR (400 MHz, DMSO-d6) (ppm) | CH3 G1-G5, s, 186H CH2 PD, m, 2H CH2OH, dd, 128H CH2O PD, m, 2H CH2O PD, m, 2H CH2O DR, m, 120H OH, br s, 64H | 1.01, 1.16, 1.18, 1.23, 1.34 1.70 3.52 3.56 3.98 4.08–4.18 4.37 | CH3 G1-G5, CH2O PD, CH2CH2CH2lys, m, 572H CH3 Boc, s, 576H CH3 Boc, s, 576H CH2NH lys, m, 128H CH2O PD, m, 2H CH2O DR + PD + CHNH lys, m, 314H αNHBoc + εNHBoc lys, m, 128H | 0.95–1.90 1.43 1.44 3.10 3.56 4.25 4.70–5.50 |
| 13C NMR (100 MHz, DMSO-d6) (ppm) | C=O G1-G5 CH2O G1-G5 Quaternary C G5 Quaternary C G1-G4 CH3 G1-G5 | 173.94, 171.73 64.27, 63.55 50.13 46.12 17.05, 16.61 | C=O esters C=ONH urethane Quaternary C Boc CH2O G1-G5 CHNH Quaternary C G1-G5 CH2NH CH2 lys CH3 Boc CH3 G1-G5 | 172.32 156.17, 155.63 79.80, 79.02 65.60–65.41 53.37 46.42 40.04 31.84, 29.57, 22.57 28.47, 28.36 17.90–14.20 |
| Elemental Analysis | C, H | 51.71, 7.01 * 51.67, 6.98 § | C, H, N | 56.78, 8.30, 6.00 * 56.76, 8.18, 6.34 § |
| Analysis | G5-PDK | ||
|---|---|---|---|
| FTIR (cm−1) | NH3+ -C=O esters NH banding | 3431 1744 1635 | |
| 1H NMR (400 MHz, DMSO-d6) (ppm) | CH3 G1-G5 + CH2CH2CH2 lys, m, 570H CH2 PD, m, 2H CH2NH3+ Lys, m, 128 CH2O PD, 3.56, 2H, CHNH3+ lys, m, 64H CH2O PD DR + CHNH3+ lys, m, 250H αNH3+ lys, br s,192H εNH3+ lys, br s, 192H | 1.03–1.99 1.70 2.76 3.56 3.99 4.10–4.50 8.20 8.82 | |
| 13C NMR (DMSO-d6, 100 MHz) (ppm) | CH3 G1-G5 CH2CH2CH2 lys CH2NH3+ Quaternary C G1-G5 CHNH3+ CH2O G1-G5 C=O | 19.33 23.14, 28.01, 31.01 40.02 47.70 53.55 67.65–67.82 170.68–173.33 | |
| Elemental Analysis | C, H, N | 41.78, 7.30, 9.10, 22.11 * 41.56, 7.00, 8.90, 22.53 § | |
| 1H NMR | MW | 20145.3 19961.2 ± 480.2 | |
| Volumetric titration | |||
| DLS 1 Analysis | Z-Ave 2 (nm) PDI 3 Z-potential 4 (ζ-p) | 203.0 ± 2.6 5 0.282 ± 0.028 5 +19.2 ± 7.3 | |
| Potentiometric Titration | Max dpH/dV 5 HCl 0.1N (mL) 6 pH 7 | 10.75 0.6 6.85 | 4.0 1.2 4.80 |
| Strains | MIC (µM (µg/mL)) |
|---|---|
| P. aeruginosa | >6.4 (>128) |
| P. fluorescens SMI1 | 0.8 (16) |
| P. putida SMA1 | 0.8 (16) |
| S. maltophylia | >25.4 (>512) |
| Strains | MIC µM (µg/mL) | Selectivity Index 2 |
|---|---|---|
| P. aeruginosa 1 * 3 | >6.4 (>128) | <13 |
| P. aeruginosa 2 # 3 | 6.4 (128) | 13 |
| P. aeruginosa 4 # 3 | 6.4 (128) | 13 |
| P. aeruginosa 7 * 3 | >6.4 (>128) | <13 |
| P. aeruginosa 9 # 3 | 6.4 (128) | 13 |
| P. aeruginosa 10 * 3 | >6.4 (>128) | <13 |
| P. aeruginosa 11 * 3 | >6.4 (>128) | <13 |
| P. aeruginosa 12 # 3 | 6.4 (128) | 13 |
| P. aeruginosa 13 * 3 | >6.4 (>128) | <13 |
| P. aeruginosa 14 * 3 | >6.4 (>128) | <13 |
| P. aeruginosa 16 * 3 | >6.4 (>128) | <13 |
| P. aeruginosa 17 * 3 | >6.4 (>128) | <13 |
| P. aeruginosa 18 * 3 | >6.4 (>128) | <13 |
| P. aeruginosa 19 * 3 | >6.4 (>128) | <13 |
| P. aeruginosa 20 * 3 | >6.4 (>128) | <13 |
| P. aeruginosa 244 § 3 | 1.6 (32) | 51 |
| P. aeruginosa 247 * 3 | >6.4 (>128) | <13 |
| P. aeruginosa 248 * 3 | >6.4 (>128) | <13 |
| P. aeruginosa 256 # 3 | 6.4 (128) | 13 |
| P. aeruginosa 259 * 3 | >6.4 (>128) | <13 |
| P. aeruginosa 402 * 3 | >6.4 (>128) | <13 |
| P. aeruginosa 403 * 3 | >6.4 (>128) | <13 |
| P. aeruginosa 405 * 3 | >6.4 (>128) | <13 |
| P. aeruginosa 426 * 3 | >6.4 (>128) | <13 |
| P. aeruginosa 427 * 3 | >6.4 (>128) | <13 |
| P. aeruginosa 428 * 3 | >6.4 (>128) | <13 |
| P. aeruginosa 432 § 3 | 1.6 (32) | 51 |
| P. aeruginosa 433 * 3 | >6.4 (>128) | <13 |
| P. aeruginosa 434 * 3 | >6.4 (>128) | <13 |
| P. aeruginosa 435 * 3 | >6.4 (>128) | <13 |
| P. aeruginosa 436 * 3 | >6.4 (>128) | <13 |
| P. aeruginosa ATCC 27853 * 3 | >6.4 (>128) | <13 |
| P. fluorescens A8 # 4 | 0.8 (16) | 101 |
| P. fluorescens SMM8 # 4 | 1.6 (32) | 51 |
| P. fluorescens SMI1 # 4 | 0.8 (16) | 101 |
| P. fluorescens SMI2 # 4 | 0.8 (16) | 101 |
| P. fluorescens SMI6 # 4 | 1.6 (32) | 51 |
| P. fragi G2 # 4 | 1.6 (32) | 51 |
| P. oleovorans # 3 | 0.4 (8) | 202 |
| P. putida 262 * 3 | 3.2 (64) | 25 |
| P. putida 407 * 3 | 3.2 (64) | 25 |
| P. putida 409 * 3 | 3.2 (64) | 25 |
| P. putida 410 * 3 | 6.4 (128) | 13 |
| P. putida SMA1 # 4 | 0.8 (16) | 101 |
| P. straminea A5 # 4 | 1.6 (32) | 51 |
| P. straminea A7 # 4 | 1.6 (32) | 51 |
| P. straminea A13 # 4 | 1.6 (32) | 51 |
| P. syringae # 4 | 0.2 (4) | 404 |
| Label * | µM | Cell Viability (%) 24 h | Cell Viability (%) 12 h |
|---|---|---|---|
| 1 | 100 | 35.9454 | 41.34742 |
| 2 | 75 | 57.4335 | 83.17176 |
| 3 | 50 | 68.9837 | 106.293 |
| 4 | 25 | 94.8178 | 124.5387 |
| 5 | 10 | 108.6001 | 126.6832 |
| 6 | 5 | 131.3011 | 98.12797 |
| 7 | 1 | 122.8936 | 94.55272 |
| Data Set | Outliers | LD50 (µM) | SI | |
|---|---|---|---|---|
| Lables | Values (µM,%) | |||
| 12 | 6, 7 | 5, 98.12797 1, 94.55272 | 95.7 | 15–478 |
| 24 | 6 | 5, 131.3011 | 80.8 | 13–404 |
Publisher’s Note: MDPI stays neutral with regard to jurisdictional claims in published maps and institutional affiliations. |
© 2021 by the authors. Licensee MDPI, Basel, Switzerland. This article is an open access article distributed under the terms and conditions of the Creative Commons Attribution (CC BY) license (https://creativecommons.org/licenses/by/4.0/).
Share and Cite
Schito, A.M.; Piatti, G.; Caviglia, D.; Zuccari, G.; Zorzoli, A.; Marimpietri, D.; Alfei, S. Bactericidal Activity of Non-Cytotoxic Cationic Nanoparticles against Clinically and Environmentally Relevant Pseudomonas spp. Isolates. Pharmaceutics 2021, 13, 1411. https://doi.org/10.3390/pharmaceutics13091411
Schito AM, Piatti G, Caviglia D, Zuccari G, Zorzoli A, Marimpietri D, Alfei S. Bactericidal Activity of Non-Cytotoxic Cationic Nanoparticles against Clinically and Environmentally Relevant Pseudomonas spp. Isolates. Pharmaceutics. 2021; 13(9):1411. https://doi.org/10.3390/pharmaceutics13091411
Chicago/Turabian StyleSchito, Anna Maria, Gabriella Piatti, Debora Caviglia, Guendalina Zuccari, Alessia Zorzoli, Danilo Marimpietri, and Silvana Alfei. 2021. "Bactericidal Activity of Non-Cytotoxic Cationic Nanoparticles against Clinically and Environmentally Relevant Pseudomonas spp. Isolates" Pharmaceutics 13, no. 9: 1411. https://doi.org/10.3390/pharmaceutics13091411
APA StyleSchito, A. M., Piatti, G., Caviglia, D., Zuccari, G., Zorzoli, A., Marimpietri, D., & Alfei, S. (2021). Bactericidal Activity of Non-Cytotoxic Cationic Nanoparticles against Clinically and Environmentally Relevant Pseudomonas spp. Isolates. Pharmaceutics, 13(9), 1411. https://doi.org/10.3390/pharmaceutics13091411

